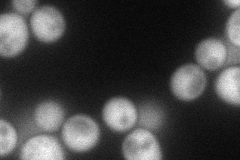
YMR316W
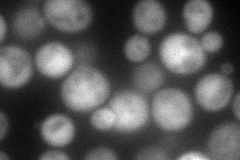
YMR316W
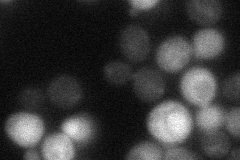
YMR316W
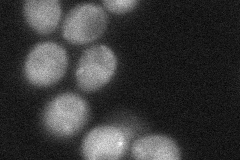
YMR316W

View description
Protein of unknown function, involved in invasive and pseudohyphal growth; green fluorescent protein (GFP)-fusion protein localizes to the cytoplasm in a punctate pattern
Localization:
Intensity:
Fold change:
Significance:
-
C’ GFP library in SD

cytosol20.9 -
N' NOP1pr-GFP in SD
cytosol75.4507 -
N' TEF2pr-mCherry in SD
cytosol116.326 -
N' NATIVEpr-GFP in SD
cytosol30.5625 -
N' TEF2pr-VC and Cyto-VN in SD
cytosol,punctate39.6152 -
C’ GFP library in SD+DTT

cytosol89.034.25Yes -
C’ GFP library in SD+H2O2

cytosol23.331.11No -
C’ GFP library in Starvation Media

cytosol52.292.5Yes -
C’ GFP library on the background of Pup2-DaMP

cytosol -
C’ GFP library on the background of CCT mutant

cytosol20.31940.971782No
